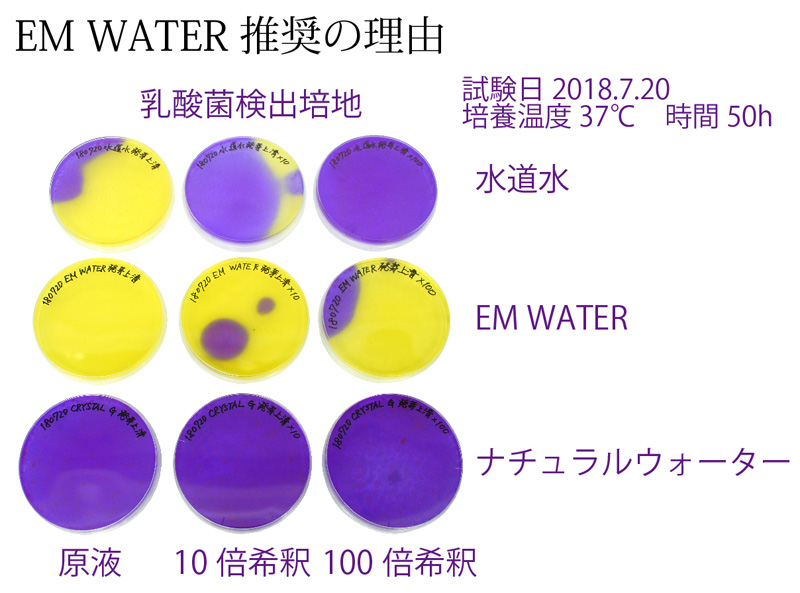

1日の飲食量は3~5kgと言われています。
1日の飲食量の多くを占めるのが主食となる炭水化物です。
現代は、麺類やパン、ケーキや菓子類など小麦を使った食品の過剰摂取が問題視されるようになり、
アレルギーやセリアック病が急増しています。
セリアック病とは、小麦・大麦・ライ麦などに含まれるタンパク質の一種グルテンが一部分解できずに小腸内の上皮細胞の絨毛を損傷させ、栄養が吸収できなくなる自己免疫疾患で、第二次世界大戦中のヨーロッパから急激に拡がり、欧米では100人に1人が罹患されていると報告されています。
日本での患者数は不明とされていますが、HIRYUセミナーでもセリアック病の方の参加が増えています。
また、糖尿病患者も急増しており、最近では発症が20代から始まっています。
日本の総人口は約1億2000万人。
20歳以上は約1億人。
糖尿病発症人口が多くなる40代以上の人口は約7700万人(成人の10人に8人)。
糖尿病患者は1000万人、糖尿病予備軍が1000万人。
実に4人に1人が糖尿病に係わっていることになります。
●厚生労働省の健康日本21では・・・
「糖尿病はひとたび発症すると治癒することはなく、放置すると網膜症・腎症・神経障害などの合併症を引き起こし、末期には失明したり透析治療が必要となることがある。さらに、糖尿病は脳卒中、虚血性心疾患などの心血管疾患の発症・進展を促進することも知られている。これらの合併症は患者の生活の質(QOL)を著しく低下させるのみでなく、医療経済的にも大きな負担を社会に強いており、今後も社会の高齢化にしたがって増大するものと考えられる。」と記されています。
●日本糖尿病学会では・・・
「糖尿病と認知症という2つの病気の間に危険な関係があることが分かってきた。糖尿病の人は認知症になりやすく、認知症になると糖尿病が悪化しやすくなる。早い時期から高血糖と低血糖を防ぎ、認知症を予防することが重要。」と注意喚起されています。
認知症はいまや3型糖尿病と呼ばれ、脳への障害は、症状が出現する10年以上も前に始まっているとみられています。
日本における認知症患者数は2012年で約462万、2025年には65歳以上の5人に1人にあたる約700万人となることが予測されています。
アレルギーや病気の発症率は低年齢化、増加傾向にあり、これに食が大きく影響しています。
また東日本大震災以降は災害も増え、2013年8月30日「数十年に1度の非常に危険な災害」を「特別警報」と制定されてから何度も発令されています。
2013年金融広報中央委員会の調査では、3世帯に1世帯、単身者の2人に1人が預金0以下であり、若い世代ほど預金が少ない傾向にあります。
発症が増えるアレルギーや病気、災害による原料高騰に逼迫(ひっぱく)する家計から、将来を不安視する割合は増加傾向にあり、日本のみならず、世界中で大きな課題となっています。
農産物で最も多い生産量を誇るお米は、世界中のどこでも無農薬で栽培する事ができ、農地を増やすことで地球環境を改善し、自然災害減少に貢献できます。
更に長期貯蔵に優れる玄米の流通が、世界の食糧問題も改善します。
酵素玄米ご飯を主食にすることでアレルギーや病気を改善し、世界中の医療費負担を軽減します。
2013年「和食」が世界文化遺産登録されました。
2020年には東京オリンピックも開催され、海外から2000万人(ベジタリアンは推定200万人)のゲストが訪れます。
HIRYUでは、世界中の一人でも多くの方に"酵素玄米ご飯"を知って頂き、地球環境と健康に貢献し、食文化の革命となることを確信し、日夜研究に励んでおり、やむことはありません。
HIRYU式酵素玄米ご飯は、十分なエネルギー、豊富な栄養の他に炊き上がりから糖尿病やメタボリックシンドローム、ダイエットに貢献できる低GI値43を実現しており、大量に生成される良質なメラノイジンは抗酸化作用(癌などを抑制)があるこのうえない主食となる炭水化物です。


※分搗きを分かりやすくしたイラストなので成分の境界は厳密ではない事を御了承下さい。
●精白米
玄米から糠層と胚芽をすべて取り除いたもの。
栄養も殆ど失い95%がデンプン質になります。
●胚芽米
本来は胚乳に栄養のある胚芽だけを残したものですが、胚芽だけ残す精米技術が難しく、七分搗きとの精米基準の曖昧さや七分搗きでも一部胚芽が残る事や、最近では「白米より栄養があり、これまでの炊飯器で玄米より美味しく炊けるご飯」としたブランディングされた商品などの販売も始まるなど、七分搗きと胚芽米の区別がなくなりつつある傾向にあります。
●七分搗き
糠層と胚芽を七割取り除いたもの。
●五分搗き
糠(ぬか)層である果皮・種皮・糊粉(こふん)層と胚芽を半分取り除いたもの。
●玄米
籾殻(もみがら)を取り除いたもの。
酵素玄米ご飯は、玄米に小豆と塩を加えて炊飯したものです。
HIRYUでは癌を抑制する抗酸化物質メラノイジン生成と血糖値上昇を抑えた低GI値を実現した炊飯方法を考案しました。(特許出願準備中)


玄米の糠(果皮・種皮・糊粉層)には他にも以下有効成分が含まれています。
●γ (ガンマ)-オリザノール
米糠の脂質に含まれ、抗酸化性と耐熱性に優れている事から食品添加物の酸化防止剤として利用されています。
コレステロールの吸収を抑制し、更年期障害や自律神経失調症の改善効果に優れており、医薬品としても利用されるほか、ビタミンCほど効果はありませんが、美白効果もあり、紫外線防止の化粧品にも利用されています。
また、皮脂腺賦活作用があり、1%含有軟膏の塗布により乾皮症やアトピー皮膚炎の症状の改善が見られ、アナフィラキシー反応(抗アレルギー)なども抑制し、炎症性腸疾患症状緩和にも有効です。
●γ -グロブリン
日本では合成洗剤が普及するまで、界面活性剤の役割として、糠に含まれるタンパク質の γ-グロブリンや研ぎ汁に含まれる乳酸菌を洗剤代わりにしてきました。
γ-グロブリンや乳酸菌は、体内に侵入してきた細菌や有害物質である抗原から守る白血球やマクロファージといった免疫細胞の抗体成分であり、脊椎動物の感染防御機構において重要な役割を担っています。
●アラビノキシラン
植物繊維のセルロースよりも高分子の糖質ヘミセルロース成分中に含まれる多糖類です。
リンパ球の一種ナチュラルキラー細胞を活性化させ、腫瘍細胞に結合し、腫瘍細胞のDNAを破壊するとされており、ガン治療や免疫機能向上の研究が進んでいます。
●γ-アミノ酪酸
γ(gamma)-aminobutyric acid の略称 GABA(ギャバ)と呼ばれています。
甲殻類の神経筋接合部、哺乳類の小脳、脊髄、大脳などに多く存在する非たんぱく質構成アミノ酸であり、トマトなど野菜、茶、米、大豆など植物にも含まれています。
グルタミン酸が興奮性の神経伝達物質であるのに対し、GABAは抑制性の神経伝達物質ですが、体外から摂取した場合は血液脳関門を通過しないため、体内で合成されたものと同等には作用しないと考えられています。
「血圧が高めの方に適する」旨の表示をした特定保健用食品が許可されていますが、それ以外の有効性については、信頼できるデータはまだありません。
●フェルラ酸
植物の細胞壁などに存在するファイトケミカルである事から、優れた抗酸化作用があり、酸化防止剤としても利用されています。
抗癌作用、血糖値・血圧降下作用、脳神経保護作用(記憶向上作用)があり、アスコルビン酸やビタミンEと共存するとより効果的です。
●イノシトール
フィチン酸は酵素フィターゼによりイノシトールとリン酸に分解されます。
イノシトールは、肝機能改善、動脈硬化予防、高脂血症改善の効果があることから、「抗脂肪肝ビタミン」とも呼ばれています。
●フィチン
植物種子などのリンの貯蔵形態であり、抗酸化作用、抗癌作用、抗腫瘍作用、老化遅延効果、排毒排泄作用、尿路結石や腎結石の予防、歯垢形成の抑制が期待され、研究が進められており、イノシトールと同時に摂取すると効果的とされています。
「フィチン酸が体内のミネラルを奪ってしまう」という間違った知識
1925年の研究から、抽出した「フィチン酸」を食品中のミネラルやタンパク質に添加したところ、強く結合したことから、玄米の胚芽や表皮に含まれる「フィチン」も強いキレート作用(金属イオン結合作用)により、体内のミネラルを結合して排泄してしまい「ミネラル欠乏症に陥るから玄米は体に悪い」という、古く誤った情報が拡散されています。
まずは「フィチン」と「フィチン酸」の違いを説明します。
「フィチン」は、カルシウムやマグネシウム、ナトリウム、リン酸などのミネラルと結合しているバランスのとれている状態であり、それ以上ミネラルを結合することはありません。
「フィチン酸」は、フィチンからカルシウムやマグネシウム、ナトリウムなどミネラルを取り除いたものであり、自然界には存在しません。
玄米に含まれているのは、フィチンであり、フィチン酸ではありません。
玄米のみならず、ゴマ・大豆・ピーナッツ・いんげん豆・えんどう豆・大麦・小麦・ひまわり・ココア・トウモロコシ・・・など色々な食品に多く含まれています。
また発芽する工程でフィチンからフィチン酸に分解されたり、体内で消化途中にフィチンからフィチン酸に分解されて、体内のミネラルと結合して排出されることはありません。
このことは幾つもの論文から「フィチン酸のキレート作用によるミネラル欠乏のリスクはない」ことが証明されており、フィチンはミネラル欠乏どころか、逆にミネラル吸収効率が上がることも証明されており、更にフィチンの消化過程で生じたフィチン酸は、現代医学において抗癌作用、心臓・血管疾患の予防効果があるとされ、特に癌に対しては天然抗癌物質IP6として注目され、これに関わる多くの書籍が出版され、書店に並んでいます。

生長機能を失った農産物の普及と不妊治療の増加
精白していない米種子を玄米といい、黒褐色の堅い果皮が外敵から守り、薄いフィルム状の種皮が水分や酸素を調節し、タンパク質と脂肪から成る糊粉層は主成分でデンプン質の胚乳を包み、発芽する際には糊粉層に含まれる酵素がデンプンを分解し、ブドウ糖に変えて、胚乳との境界にある胚盤がブドウ糖を吸収し、胚芽を生長させます。
(研ぎ汁が白く濁るのは糊粉層が脱落したものです。)
「米に健康と書いて糠(ヌカ)」と読むのに対して「米が白いと書いて粕(カス)」と読むように、精米すればする程に糖質だけになるので食べやすくはなりますが、栄養と生長機能を失い、発芽もできず、賞味期限も短くなります。
お米に限らず、小麦なども同様です。
最近は果物にしても「種無し」が多くなり、野菜も一度しか収穫できないF1種が殆どです。
国民の2組に1組が不妊に悩んでおり、3組に1組が治療している傾向に食の影響が懸念されています。
HIRYUでは、農薬や化学肥料を使用せず、生長機能を失っていない還元力のある農作物に拘った酵素玄米菜食を指導させて頂いており、これまでに不妊治療を何度しても出産まで辿りつけなかったカップルが何組も念願の子宝に恵まれています。
不妊でお悩みの方は、是非1年間ほど食を改善してみて下さい。
何度も不妊治療されている女性には特にカラダを休ませる意味でもお勧めします。
他にも、幼い女子が早すぎる初潮、乳房が膨らんでしまう男子、男性の乳癌など、鶏・豚・牛・羊など畜産に使用される肥育ホルモン剤が原因ではないかという報道もされています。
カラダの細胞や組織は食べたものでつくられており、いつの時代にも起こる健康問題の背景には食の影響が大きく関わっており、食産業と医療産業は日々発展・進化をし続けています。

精白米は「米が白いと書いて粕」と読む通り、ビタミンやミネラルなど95%の栄養素を失った殆どがデンプン質です。
デンプンは唾液に含まれている消化酵素(アミラーゼ)によって麦芽糖に分解され、分解できなかったデンプンは十二指腸で膵液によって麦芽糖に分解され、小腸で消化酵素マルターゼによって麦芽糖からブドウ糖に分解され、小腸の毛細血管から吸収され、肝臓で一部は貯蔵多糖グリコーゲンとなり大人で100~120gまで蓄えられ、残りはエネルギーとなり、余分なブドウ糖は脂肪になります。
糖質の1日の必要量は100gです。
白米ご飯1膳150gからは55.2g、玄米ご飯1膳150gからは51.3gの糖質に変わります。
糖質量を比較するとあまり変わりませんが、これをGI値で比較します。
GI値とは、ブドウ糖50gを摂取してからの血糖値(血液中のブドウ糖濃度を示す値)を2時間測定し、血糖変動曲線を描くグラフ面積を100%とした場合に被験食品のグラフ面積が何%あるかという数値であり、83%以上は高GI値、65~82%は中GI値、64%以下は低GI値とされる健康目安の指標です。
パン(フランスパン93、食パン91)や麺(うどん85、ラーメン73、パスタ65)、ジャガイモ91など主食とされる炭水化物は糖質に変換されるので、どうしてもGI値が高いので太りやすく、更に日本人は膵臓のβ細胞機能が弱い傾向があり、インスリンを分泌する能力が欧米人の約半分とされる人もいるので、高GIの過食が続くと、血糖上昇の度合いに合わせ、ほぼ比例して分泌されるインスリンが枯れてしまい、糖尿病を始め色々な病気を発症させてしまいます。

上のグラフは、白米ご飯、玄米ご飯、HIRYU式酵素玄米ご飯のGI値を測定した結果です。
白米ご飯は殆どがデンプン質なので高GI値88になりました。
玄米ご飯は、食物繊維・ビタミン・ミネラルが多く含まれているので中GI値77になりました。
従来の圧力鍋で炊飯した酵素玄米ご飯は、小豆の糖質が加わるのでGI値が高くなるように思われますが、メラノイジン生成に糖化が関わるため玄米ご飯よりやや低い中GI値74となりました。
HIRYU式酵素玄米ご飯は、炊き上がりからメラノイジンが大量に生成されるので低GI値43となりました。
HIRYU式酵素玄米ご飯は健康的かつ経済的でもあり、日本のみならず、世界に貢献できる主食として研究を進めています。
GI値やGL値の情報についての注意
GI値は、血液中のブドウ糖濃度を示す血糖値が直接反映されるものなので、総体的な食事をした被験者の血糖値を測定するのが本来です。
しかし、ご家庭でその都度測定するのは不可能な事から、主食となる炭水化物の割合が多い米類・パン類・麺類などに目安となる数値を設定し、糖尿病やメタボリックシンドロームなどの予防に役立てる事を目的としています。
炭水化物含有量が少ない野菜などは、これらと比較するには適当でない事から、GI値×炭水化物量÷100で計算するGL値(グライセミックロード)もありますが、調理方法や複数の食材の組み合わせ、食べる順番でも血糖値は大きく変化しますし、低GI値の食品であっても、摂取量が多ければ血糖値が上昇します。
ブドウ糖と同時に水分を摂取すると小腸へ素早く移動するので血糖値が上昇しやすくなる事や、直接吸収されるブドウ糖に対して代謝経路が多く、血液中濃度がブドウ糖の500分の1ほどしかない果糖を始め、ショ糖、麦芽糖、乳糖などブドウ糖に変換されない糖質や脂質がGI値やGL値に対象とされていない事、運動量や代謝速度の違い、臓器や細胞の機能性の個人差、そして何より数値はガイドラインであり本人の測定数値でないと意味がありません。
情報が拡散されているGI値やGL値の一覧表を見る時は、被験者の状態、引用元、人種や食品の性質が違う海外データではないかなど、よく確認する必要があります。

還元力のあるHIRYUの無農薬の玄米と小豆と塩を専用炊飯器CUCKOO NEW 圧力名人DXで発芽させて炊飯することで、アクリルアミドを発生させず、アミノ酸(アスパラギンやグリシンなど)とブドウ糖によるアミノカルボニル反応の一種であるメイラード反応を起こし、褐色物質メラノイジンを生成し、ご飯を赤く炊き上げます。
これまでは、メラノイジン生成に72~74℃の保温で3~4日間の熟成期間が必要な上に、熟成させた分だけ水分量が損なわれてしまい、賞味期限が8日程でしたが、 圧力名人DXは炊飯時からメラノイジンを大量に生成できるので、炊きたてから召し上がれて、更に14日経っても90%も水分量が保持できるので、1度の炊飯で2週間も召し上がる事ができます。
メラノイジンは抗酸化作用、活性酸素消去活性、ヘテロ環アミノ化合物(発癌物質)に対する脱変異原活性( DNA や染色体に損傷を与え突然変異を起こす物質を変異させる効果)があります。
またメイラード反応によって生じたアミノ酸の一種であるトリプトファン・グルコース反応液の抗酸化能は、ビタミンEよりも強く、合成抗酸化剤のBHA、BHTに匹敵する効果があるとされています。
味噌・醤油・酢・味醂・納豆などの発酵食品の着色もアミノカルボニル反応によるメラノイジンであり、着色度が高いほど効果は高く、β-カロテンやビタミンCが含まれる生野菜や漬物など副菜を付け合わせる事で、完全食となり、あらゆる病気やアレルギーの抑制効果が期待されており、太りすぎや痩せすぎの体重を適正体重に戻しながら健康的なカラダをつくりだします。
メラノイジンの多彩な生理機能要点(日本栄養・食糧学会誌"メラノイジンの生理機能"参照)
●肝臓及び血液のコレステロール低下作用
●耐糖能改善効果(血糖値の急激な上昇を防ぐ⇒糖尿病予防)
●インスリン分泌促進(糖尿病予防)
●アンジオテンシンⅠ変換酵素の活性阻害(血圧上昇抑制)
●リパーゼ(脂質分解酵素)活性阻害(肥満や高脂血症予防)
●効酸化作用(還元力が強い)
●活性酸素消去能
●発癌物質ニトロソアミン生成抑制

炊き上がりのメラノイジン比較
圧力名人DXと圧力名人はHIRYU推奨の材料とレシピで炊飯し、レトルト以外の炊飯器と炊飯鍋は、各メーカー推奨の材料(玄米・小豆・塩など)と炊飯方法に従い炊飯しています。
メラノイジンは生成されるほど赤くなります。
HIRYU式DX炊飯は3~4日の熟成の必要がなく、炊き上がりから健康的(低GI値)で美味しく召し上がれます。





熟成中の水分量と減少率の保温性能を比較
●HIRYUではモチモチ感があり美味しく食べられる水分量は94%以上としています。
●賞味と言うにふさわしい食べられる限界の水分量は90%以上です。
●81~89%は食べても美味しいとは感じられませんが召し上がることはできます。
●80%以下になると硬くて食べられません。
メラノイジン生成のための熟成期間3~4日とされていますが、「美味しい期限~食べられる期限」で見ると、他社炊飯器で4~8日、圧力鍋で3~6日ですが、HIRYU式圧力名人で6~10日、HIRYU式DX炊飯ならば9~14日、賞味期限があります。
尚、圧力鍋の場合は保温器に酵素玄米ご飯の適正保温温度72~74℃に対応する保温器が利用されますが、保温器の購入や置き場所(46×38×25cm)そしてご飯を移す手間があり、更に故障の際メーカーは、故障原因となる塩を使う酵素玄米ご飯の修理保証はしていません。
また、一般炊飯器で保温できるのは1日でしかなく、期待するメラノイジン生成に至れず、カビが発生するのでオススメしません。

酸化とは
体内細胞の水素イオンが奪われている状態なので、細胞や組織が酸化してしまい、老化、病気を促進させます。
還元とは
酸化した細胞に水素イオンを与え、元の細胞に戻すので、老化、病気を改善させます。
酸化還元電位(Oxidation-reduction Potential; ORP)とは
酸化させる力と還元させる力との差を電圧(mV)で測定します。
酸化力が強いほど電圧値はプラスになり、還元力が強いほど電圧値はマイナスになります。
例えば、この日測定の水道水の場合、+512mVの酸化傾向にあります。
入浴後に化粧水を使う理由は、肌から奪われた水素イオンを補う為です。
血液のORPは+250mV以下です。
血液を酸化させずに還元する為には+250mV以下の食事や入浴が健康の秘訣です。
HIRYU式酵素玄米ご飯の炊きたてのORPを測定した結果は+196mV!
還元しているご飯ができました。
炊飯に利用される水はEM WATERを推奨しています。
●EM WATERはこちらをCLICK
●還元力のある玄米はこちらをCLICK
●還元力のある小豆はこちらをCLICK
●還元力のある塩スパソルトはこちらをCLICK
●還元機能のある炊飯器DXはこちらをCLICK
「水道水」「EM WATER」「ナチュラルウォーター」を使ってHIRYU式酵素玄米炊飯しました。
健康によいとされる酵素玄米ご飯は乳酸菌が豊富です。
乳酸菌は、リンパ球(T細胞・B細胞・NK細胞・形質細胞)、マクロファージ、好中球(ミクロファージ)、樹状細胞など免疫細胞の働きを助け、免疫力をアップさせ、それらが血管に浸透して酸化している組織や細胞の隅々にまで還元し、体質を改善する働きがあります。
●プレート左は、炊飯前発芽後の玄米と小豆と塩の浸水液試料を塗布し、培養した乳酸菌検出培地ですが、EM WATERでは乳酸菌が増えて活発化した(培地色が黄色)のに対し、ナチュラルウォーターでは乳酸菌が全く増えませんでした(培地色が紫色)。
意外にもナチュラルウォーターより水道水の方が乳酸菌が増えることがわかりました。
●プレート中央は、純水で10倍に希釈した試料を用いた乳酸菌検出培地ですが、こちらでは水道水でも乳酸菌がほとんど増えませんでした。
●プレート右は、純水で100倍に希釈した試料を用いた乳酸菌検出培地ですが、EM WATERは10倍に希釈した時とほぼ変わらず、体質改善に非常に効果が期待できます。
●EM WATERについてはこちらをCLICK
●EM WATERの原液となるEMX GOLDについてはこちらをCLICK


上記検査項目以外に毎日同時刻に血圧、安静時心拍数、体重、体脂肪、体温を計測しました。
酵素玄米菜食の判定は想定通り非常に良い結果でした。
メラノイジンがしっかり生成されている酵素玄米ご飯は完全食と言われている事から、酵素玄米ご飯だけを12日間食べ続けた結果も、主成分が炭水化物とは思えない良い結果となりました。
この他にも被験者2名に10日間酵素玄米ご飯だけを食べ続けた実験結果も同様でした。
しかしHIRYUでは、酵素玄米ご飯に野菜や果物からビタミンCとβ-カロテンを必ず摂る事をすすめており、酵素玄米菜食を完全食としています。
正常値でない人は、是非、無農薬・無添加に拘った酵素玄米菜食を一カ月間試してみて下さい。体質改善が実感できるはずです。
●還元力のある野菜はこちらを☞CLICK
医療も通信の時代!HIRYUでは血液検査のサービスを始めました!
自宅で検査を行い、検査結果は1週間以内に携帯電話かパソコンでスピード確認でき、1週間後には検査結果が自宅に郵送されます。
気になる事があれば食事を中心とした生活習慣のメールサポートを受けられます。
サービスを継続する事で、どのような生活習慣が健康に善いのか悪いのか実践から学べる様になり、健康についての知識や関心が高まり、健康を維持できる様になります。
異常値が改善できない場合は、病院で診察を受け、悪い項目が明確なので早期治療が可能となり、無駄な検査費用も軽減できるので、大病予防に最も効果的な対策です。
1年に1度の健康診断では早期発見が間に合わない程に病気の進行が早い時代です。
癌保険や生命保険など病気になってからの対策よりも、病気にならない為の予防が大切です。
検査は自宅で!保険よりも予防!
HIRYUの健康サポートサービスを是非ご活用下さい。☞CLICK








